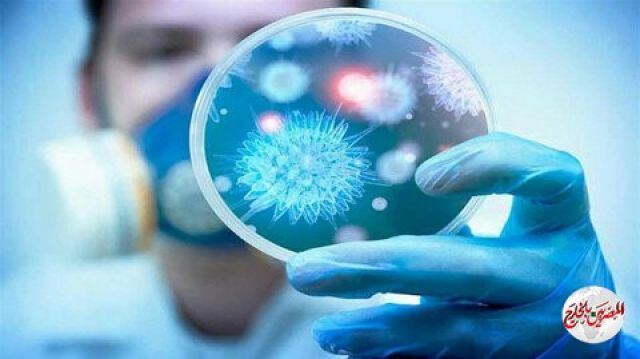
اكتشاف فيروس "كورونا" في مكان خطير بالجسم يحل لغز وفاة عدد من المتعافين!

اكتشاف فيروس "كورونا" في مكان خطير بالجسم يحل لغز وفاة عدد من المتعافين!

بحسب قناة فوكس نيوز,أكدت دراسة إيطالية نٌشرت هذا الأسبوع في مجلة "medXriv"، أن فيروس كورونا يمكن أن يغزو الخلايا العضلية، أو خلايا أنسجة عضلة القلب، وطالبت الأشخاص الذين تعافوا من الفيروس مراقبة أنفسهم جيدا فقد يكونوا أُصيبوا بأمراض القلب
وأوضح الباحثون الإيطاليون أنه تم رصد ست حالات وفاة بفيروس كورونا بين البالغين الذين كانوا يتمتعون بصحة جيدة سابقًا، نتيجة إصابتهم بأمراض في القلب، وأشاروا إلى أن فيروس كورونا أصاب القلب بتشوهات حتى بعد شفائهم من المرض.
وكتب مؤلفو الدراسة: "تم اكتشاف وجود فيروس كورونا في خلايا عضلة القلب بشكل ثابت"، وأضافوا أنه يجب مراقبة صحة القلب لدى مرضى كورونا الذين تماثلوا للشفاء، لمعرفة أثره على المدى الطويل.
وكانت دراستان تم نشرهما في وقت سابق من هذا الشهر، دعمتا هذه الدراسة، وأكدتا أنه تم العثور على الفيروس في أنسجة القلب، مما يمكن أن يؤثر على أنسجة عضلة القلب، ويسبب مضاعفات تهدد حياة المرضى.
وجدير بالذكر وثق أطباء وخبراء برازيليون في هذه الدراسة، وفاة طفلة تبلغ من العمر 11 عامًا كانت مصابة بحالة التهابية عند الأطفال مرتبطة بفيروس كورونا، وأكدوا أن الطفلة أصيبت بقصور في القلب وتوفيت بعد يوم واحد من دخولها المستشفى.


















